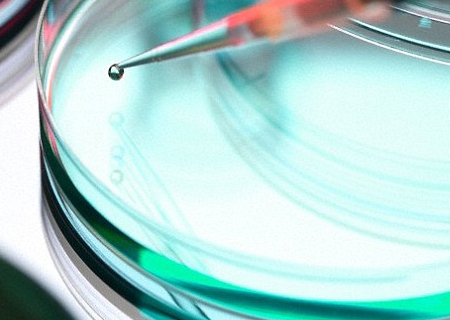

Intestino é criado em laboratório: sem rejeição
Foto: Andrew Brookes/Corbis
Cientistas criaram um pedaço de intestino humano em laboratório.
A descoberta abre o caminho para novos tratamentos para distúrbios intestinais como a doença de Crohn e até mesmo o câncer.
A criação foi feita com células-tronco adultas, que os pesquisadores utilizam para o crescimento de fragmentos de tecido chamado Organóides.
São uma espécie de ‘botões’ tridimensionais de órgãos, com o potencial de se transformarem em tecidos com determinadas funções.
Em seguida o material foi transplantado em camundongos e se transformou num intestino funcional.
O cientista-chefe, Dr. Michael Helmrath, do Programa de Reabilitação Intestinal do Hospital Infantil de Cincinnati, em Ohio, EUA, disse que a descoberta pode ter muitas implicações.
Futuro
“Isso fornece uma nova maneira de estudar as muitas doenças e condições que podem causar falência intestinal , de distúrbios genéticos que aparecem mais tarde, tais como câncer e doença de Crohn.
“Os estudos podem garantir que no futuro os tecidos em crescimento possam substituir o intestino humano danificado. Espera-se que um dia, os médicos criem órgãos como “peças de reposição”, utilizando células do próprio paciente para reparar o tecido que está doente.
Criação em laboratório
Os pesquisadores modificaram geneticamente as células do sangue e da pele humana para criar células-tronco pluripotentes ( iPSCs ).
Estas são as células-tronco que revertem para um estado embrionário imaturo.
Foram feitos em Organóides, ou as células intestinais, e em seguida, enxertados nos rins de ratos.
Isso permitiu que as células crescessem e se multiplicassem por conta própria, no tecido intestinal humano, de acordo com o estudo publicado na revista Nature Medicine.
Após seis semanas, os feixes de células foram maiores do que próprios rins dos ratos e se tornaram os tipos necessários para desempenhar as funções associadas à absorção e digestão dos alimentos em seres humanos de tecidos.
Os Organóides também desenvolveram camadas de músculos vitais para espremer alimentos através das células do intestino, e nervosas, para fazerem os músculos se contraírem.
Os feixes de células não foram rejeitados pelos camundongos, porque os animais foram geneticamente alterados para que os seus sistemas imunológicos aceitassem os tecidos humanos.
Tratamentos futuros podem usar iPSCs derivadas de células da pele do próprio paciente, eliminando o risco de rejeição de transplantes e a despesa de medicação ao longo da vida .
Num curto prazo , espera-se que o estudo acelere o desenvolvimento de drogas e de progressos na medicina.
Com informações do Daily Mail.

Butantan amplia para 10 cidades a aplicação da vacina contra chikungunya
Polilaminina será distribuída pelo SUS, após aprovação da Anvisa, diz dra. Tatiana Sampaio
Repórter cadeirante entrevista Dra. Tatiana Sampaio sobre a polilaminina e abraço emociona; vídeo
Dra. Tatiana da Polilaminina estará no Roda Viva, na estreia de Ernesto Paglia, nesta segunda-feira
Paraplégico fica de pé pela primeira vez 1 mês após injeção da polilaminina; vídeo
Vacina contra dependência de crack e cocaína: Brasil vai começar testes em humanos
Bombeira se aposenta, ganha homenagem e se emociona: “hora de cuidar de mim”; vídeo
Começa Feirão Limpa Nome; veja onde negociar dívidas com 99% de desconto
20 anos sem Gisberta, a brasileira que virou música e obrigou Portugal a combater a transfobia
Criança interrompe missa com gatinho e pede para o padre abençoar o felino; vídeo
Autista, filha de doméstica e pai analfabeto, é aprovada em Medicina: “quebra de ciclo histórico”
Desconhecidos recolhem refrigerantes derramados na pista, devolvem ao motorista e vídeo bate 7 milhões